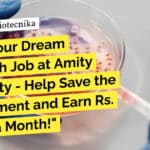
Amity Institute of Biotechnology Research Assistant Job For Biotech, Biochem, Microbiology – Apply Now "Land Your Dream Research Job at Amity University - Help Save the Environment and Earn Rs. 30,000 a Month!"

Home Search
microbiology - search results
If you're not happy with the results, please do another search
Freshers Biotech, Biochem, Microbiology Job Opportunity at Clarivate, Apply Online
Biochem Freshers Job Opening - Biotech & Microbiology Apply at Clarivate
Associate Content Editor - Biomedicine
We are looking for an Associate Content Editor to join our Biomedicine team in...
CSIR-CFTRI Biotech, Biochem, Microbiology Project Associate Job – Apply Online
CFTRI Biotech Project Associate Job - Biochem & Microbiology Apply Online
CFTRI Biotech Project Associate Job - Biochem & Microbiology Apply Online. Interested and eligible...
Amity Institute of Biotechnology Research Assistant Job For Biotech, Biochem, Microbiology – Apply Now
AIB Amity University Research Assistant Job For Biotech, Biochem, Microbiology - Apply Now
Advertisement Date: 09.04.2024
Amity University Uttar Pradesh, Noida invites applications for
AMITY INSTITUTE OF...
Beam Suntory Executive QA Job For Food Tech, Biotech, Biochem & Microbiology – Apply...
Beam Suntory Executive QA Job For Food Tech, Biotech, Biochem & Microbiology - Apply Online
Executive QA
Date: Apr 10, 2024
Location: Indore, MP, IN
Company: Beam...
Freshers Job at Panacea Biotec Pharma Ltd – MSc Biotech & Microbiology Apply For...
Freshers Job at Panacea Biotec Pharma Ltd - MSc Biotech & Microbiology Apply For QC Executive
JUNIOR EXECUTIVE - QUALITY CONTROL (MICROBIOLOGY)
MANUFACTURING UNIT, Baddi, Himachal...
Govt NCT Delhi ILBS Microbiology, Life Sciences, Biotech, Biochem Project Assistant Recruitment – Applications...
Govt ILBS Project Assistant Job For Life Sciences, Microbiology, Biotech & Biochem - Apply Now
INTERVIEW FOR THE POST OF ‘PROJECT ASSISTANT’
UNDER PROJECT FUNDED BY...
United Breweries Ltd BSc Microbiology Shift Brewer Job Opening, Apply Online
United Breweries Ltd BSc Microbiology Shift Brewer Job Opening, Apply Online
Shift Brewer
United Breweries Ltd. · Kalyani, West Bengal, India
Role Title: Shift Brewer
Educational Qualification: MSC,...
Pepsico India Microbiology, Food Tech SC QC Job Opening – Apply Online
Pepsico India Microbiology, Food Tech SC QC Job Opening - Apply Online
Assistant Manager – SC Quality Control
Pune, India
APPLY NOW
BACK
Assistant Manager – SC Quality Control
Pune,...
Colgate-Palmolive Biological Sciences & Microbiology Job Opening, Apply Online
Colgate-Palmolive Biological Sciences & Microbiology Job Opening, Apply Online
Colgate-Palmolive Biological Sciences & Microbiology Job Opening, Apply Online. Interested and eligible applicants can check out...
TMC-ACTREC BSc, MSc, BTech & MTech Biotech, Life Sciences, Microbiology JRF Job – Attend...
TMC-ACTREC BTech Biotechnology JRF Job - Attend Walk-In
TATA MEMORIAL CENTRE
ADVANCED CENTRE FOR TREATMENT, RESEARCH AND EDUCATION IN CANCER
Kharghar, Navi Mumbai- 410 210
www.actrec.gov.in
Phone No:...
Discover Your Dream Job as a Microbiology Manager at MS Clinical Research – Apply...
Microbiology Manager MS CLINICAL RESEARCH, Apply Online
Microbiology Manager MS CLINICAL RESEARCH · Bengaluru, Karnataka, India
About the Job
Position: Microbiology Manager
Location: MS Clinical Bangalore
About Us: MS...
Johnson & Johnson Quality Control Executive Opportunity – BSc, MSc Life Sciences & Microbiology...
J&J QC Executive Job Opening For Microbiology & Life Sciences, Apply Online
Job Description - Executive, Quality Control (2406170982W)
Executive, Quality Control-2406170982W
Description
Executive, Quality Control - Aurangabad
Caring...
Sun Pharma Microbiology QC Walk-In-Drive
Sun Pharma Microbiology QC Walk-In-Drive
WALK - IN Drive at SUN PHARMA, DEWAS
Great chance to work with India's No.1 Pharmaceutical company Sun Pharma @ Dewas
We...
Cipla BSc Team Member Job Opening For Microbiology Candidates – Apply Online
Cipla BSc Team Member Job Opening For Microbiology Candidates - Apply Online
Junior Team Member - Microbiology
Posting Date: 1 Apr 2024
Country: India
State: Sikkim
Location: Rangpo
Req Id:...
Trainee Microbiology (Analytical Lab) Opportunity at Endo – Apply Online
Trainee Microbiology (Analytical Lab) Opportunity at Endo - Apply Online
Job Title: Trainee Microbiology (Analytical Lab)
Locations: India - Digha
Time Type: Full-time
Posted On: Posted Today
Job Requisition...